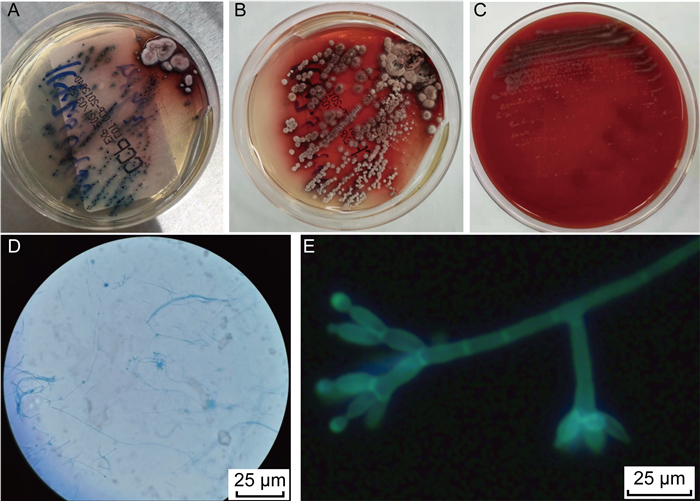

马尔尼菲篮状菌病(talaromycosis)是由马尔尼菲篮状菌(Talaromyces marneffei,TM)感染引起的侵袭性真菌病,一般分为局限型和播散型,好发于免疫低下人群[1]。播散型马尔尼菲篮状菌病既可累及皮肤黏膜,也可累及呼吸系统、消化系统及淋巴系统等,临床上多表现为发热、皮疹、体重减轻和肝脾淋巴结肿大等症状[2]。因该病临床表现与器官受累情况相关,表现多样化,且与肿瘤及结核菌感染等疾病鉴别困难,明确诊断的患者多已播散至全身,导致此病的病死率高[3]。我院近期收治1例“咽痛”患者,反复诊治2月余,最终被确诊为播散型马尔尼菲篮状菌病。现结合文献复习报道如下。
1 病例资料 1.1 患者概况患者,男,56岁。因“咽痛2月余”于当地医院就诊,吞咽口水或进食时咽痛明显,偶尔呛咳,起初不伴声音嘶哑、进食梗阻、发热、肢体活动障碍等症状。既往有糖尿病且血糖控制不佳,无艾滋病及免疫抑制药物服用史。2021年2月于当地医院查白细胞指标值正常,血红蛋白81 g/L。喉镜提示左侧声带后上方见囊肿样物,声带固定。鼻咽镜可见鼻咽部糜烂、溃疡,病检提示局部区域坏死、炎性渗出、肉芽组织增生。胃镜提示胃体多发溃疡,食管未见异常,病理检测提示为黏膜组织慢性炎症。给予对症治疗,患者“咽痛”无明显好转,故在2021年4月4日于我院就诊。
入院时查体生命体征平稳,神清,皮肤苍白,巩膜无明显黄染,无皮疹及出血点,无肝掌及蜘蛛痣;双肺呼吸音粗,未闻及干湿啰音;心脏听诊无异常;腹软,全腹无明显压痛、无反跳痛,肝脾肋下未触及,移动性浊音阴性,肠鸣音正常,双下肢无水肿。入院查白细胞指标值正常,血红蛋白84 g/L,C反应蛋白(C-reactive protein,CRP)15.9 mg/L,降钙素原正常,肝功能正常,肿瘤标志物全套均正常,乳酸脱氢酶正常,血清β2微球蛋白4.6 mg/L。人类免疫缺陷病毒(human immunodeficiency virus, HIV)抗体阴性。胸部及全腹部计算机断层扫描(computed tomography,CT)提示肺下叶背侧坠积性炎性改变,双侧胸膜增厚粘连;胃壁增厚;纵隔、双侧腋窝、腹膜后及肠系膜走行区淋巴结增多、肿大,较大者2.0 cm,不排除转移性病变;双侧肾上腺明显增粗,不排除转移性病变;腹盆腔积液(见图 1)。

|
|
A: Increased and enlarged lymph nodes in neck in CT scanning. B: Increased and enlarged lymph nodes in axilla in CT scanning. C: Increased and enlarged lymph nodes in mediastinum in CT scanning. D: Bilateral adrenal gland thickening and increased and enlarged lymph nodes in mediastinum in CT scanning. 图 1 胸部及全腹部CT检查结果(2021年4月) Fig. 1 CT examination results of chest and abdominal (April 2021) |
入院后,患者诉腹痛,腹胀,间断解柏油样便,2021年4月6日出现声音嘶哑、发热、咳嗽,咳白黏痰,氧饱和度偏低,并左侧眼睑上抬困难,伴有左侧眼球活动受限、轻度吐词不清、口角歪斜。4月9日患者右下颌、右颈部及左前额出现多个绿豆大小的红色毛囊性丘疹及脐凹样疹,局部皮疹中央可见针尖大小黑痂或浅溃疡;查体颈部及腋窝可触及多发淋巴结肿大。
1.2 检查结果进一步完善检查,结果如下。β-D-葡聚糖(β-D-glucan, G)试验:127 pg/mL,半乳甘露聚糖(galactomannan, GM)抗原试验:1.67 s/co;头颅、鼻咽部及颈部磁共振成像(magnetic resonance imaging,MRI)提示:延髓左侧异常信号,不排除转移性病变,前颈部多发淋巴结,部分肿大、融合(见图 2)。喉镜提示:双侧圆枕见新生物,其表面覆盖白色伪膜样物,左侧咽侧壁、舌根部隆起,左侧声带后上方见囊肿样物,双侧梨状窝光滑,左侧声带固定,右侧声带运动正常(见图 3)。2次颈部及腋窝淋巴结穿刺涂片见细胞内外大量圆形、卵圆形直径约2~4 μm的孢子,多呈两头钝圆、中间有横膈的腊肠形,考虑为马尔尼菲篮状菌病(见图 4)。与此同时血培养瓶内涂片镜检下见丝状真菌生长。随后,将淋巴结穿刺物分别在25 ℃和37 ℃沙保罗培养基中培养1周,观察到在25 ℃培养条件下,菌落呈黄绿色,并见红色可溶性色素深入培养基中,显微镜下见典型的扫帚状有隔菌丝及端生分生孢子;在37 ℃培养时,菌落为白色、褐色奶油状,无色素产生,显微镜下呈带横隔的腊肠形孢子(见图 5)。

|
|
A, C: Increased lymph nodes in the anterior neck, partial enlargement and fusion in MRI examination. B, D: Abnormal signal on the left side of medulla oblongata in MRI examination. 图 2 头颅、鼻咽部及颈部MRI检查结果(2021年4月) Fig. 2 MRI examination results of the head, nasopharynx and neck (April 2021) |

|
| Laryngoscopy showed neoplasm in bilateral round occipital, the surface of which was covered with white pseudomembranous material, and the left lateral pharyngeal wall and tongue base were raised, cyst-like material was seen behind and above the left vocal cord. The bilateral piriform fossa was smooth, the left vocal cord was fixed, and the right vocal cord movement was normal. 图 3 患者喉镜下表现 Fig. 3 Laryngoscopic findings |

|
|
A, C: The lymph node puncture smear showed a large number of round and oval-shaped spores with a diameter of 2-4 μm inside and outside the cells, most of which were in the shape of dachshund with two obtuse round ends and a diaphragm in the middle, which was considered as Talaromycosis. B: Filamentous fungi can be seen in blood culture smear under microscope. 图 4 淋巴结穿刺涂片及血培养检查结果 Fig. 4 The results of lymph node puncture smear and blood culture examination |
|
|
A, B: When cultured at 25 ℃, the colonies were yellow green, and red soluble pigments were seen in the medium. C: When cultured at 37 ℃, the colonies were white, brown and creamy. D, E: Red brown colonies were pasted and stained with both gossypol lactate and fluorescent dye, and then observed under microscope. There were obvious broom branches, double or single whorls, conidia were oval or round, and there were obvious spore interconnects. 图 5 淋巴结穿刺物培养及镜检结果 Fig. 5 The results of lymph node puncture specimens culture and fluorescence microscope observation |
综上所述,考虑此患者为播散型马尔尼菲篮状菌感染,予两性霉素B诱导治疗2周,患者症状好转,并予口服伊曲康唑以巩固治疗,患者皮肤、消化道及呼吸道症状缓解,无吐词不清、口角歪斜等情况,半年后随访左侧眼睑上抬基本正常,体力、体重增加。
2 讨论 2.1 马尔尼菲篮状菌病的概念马尔尼菲篮状菌为条件致病真菌,是温度依赖性双相菌[4]。25 ℃时,该菌呈多细胞菌丝相(传播相)生长,有帚状枝及分生孢子链,37 ℃时呈酵母相(致病相),为卵圆形、椭圆形酵母样孢子,孢子中间可见分隔,呈腊肠形[5]。马尔尼菲篮状菌可在土壤中长期存活,分生孢子多经呼吸道吸入人体内,从菌丝相转变为酵母相从而致病,因此人感染后不会立即发病,须经历1~3周的潜伏期[5]。人群普遍易感马尔尼菲篮状菌,免疫力正常的人群感染后可清除,免疫力低下者定植后感染进一步播散或潜伏感染后再活化[6-7]。
马尔尼菲篮状菌孢子进入人体后与黏多糖结合定植,通过巨噬细胞吞噬及抗原呈递使T细胞致敏,进而释放细胞因子活化巨噬细胞来杀灭真菌,在此过程中导致机体自身局部组织坏死[8-11]。若机体免疫低下无法杀灭马尔尼菲篮状菌,真菌则在巨噬细胞内繁殖,刺激巨噬细胞系统增生并循环播散,造成全身多系统感染,表现为肝、脾、淋巴结肿大,器官组织灶性坏死[12-13]。由于数据有限,尚不清楚马尔尼菲篮状菌病在我国人群中的真实发病率,此病多发生于南部,主要发生于艾滋病患者或其他免疫抑制的患者中,少部分发生于免疫功能正常者[6-7, 14-15]。本例报道患者无HIV感染,经反复追问,得知其患病前数月曾至河必岭(隶属我国广西壮族自治区),而广西壮族自治区为马尔尼菲篮状菌感染流行区。考虑患者当时为潜伏感染,返乡后其糖尿病控制不佳、连续多天劳累导致免疫力下降后逐渐发病。
2.2 马尔尼菲篮状菌感染分类及临床表现马尔尼菲篮状菌感染分为局限型感染和播散型感染。局限型感染病灶常位于肺部、皮肤、淋巴结,早期可表现为发热、咳嗽、消瘦、贫血等不典型症状[3]。播散型感染则可累及呼吸系统、消化系统、皮肤黏膜、骨关节及中枢神经系统等,病死率高[16]。患者上呼吸道受累,可表现为咽痛、声嘶、吞咽困难、咽喉肿块、黏膜溃疡、颈部淋巴结肿大等,若感染累及下呼吸道,可表现为发热、咳嗽、咳痰等类似“肺炎”的症状,常见白痰,偶咳黄痰或出现痰中带血,也可有胸痛和呼吸困难等表现,严重时出现呼吸衰竭,听诊呼吸音弱,常闻及湿啰音。腹痛、腹胀、腹泻为马尔尼菲篮状菌侵犯消化系统的常见表现,部分患者会出现消化道出血、腹水、发热、消瘦;感染累及肝脏时,患者可有发热、腹胀,查体可触及肝大,生化检查可见肝功能不全[17-19]。马尔尼菲篮状菌感染患者皮肤损害较为常见,皮损最常累及面耳部及肢体,典型症状为脐凹样皮疹、坏死性丘疹、痤疮或毛囊炎样改变,甚至皮肤溃疡,黏膜损害与皮肤表现类似,口腔、咽喉、消化道和生殖器黏膜常受累[17-19]。此外,马尔尼菲篮状菌病患者多可出现浅表淋巴结、腹腔淋巴结及肺门纵隔淋巴结肿大,纵隔或肺门淋巴结肿大直径可达1.0~2.0 cm,一般无明显坏死性改变,应与结核、淋巴瘤等疾病相鉴别[20]。其他表现如溶骨性损害[21-22]、泌尿系统感染[23]、中枢神经系统肉芽肿或脓肿[24-26]等较少见。
本例报道中,患者起初仅表现为“咽痛”,经鼻咽镜及喉镜检查发现鼻咽部溃疡、圆枕新生物(覆伪膜样物)、声带后上方囊肿样物,均为马尔尼菲篮状菌感染上呼吸道表现,后在病程发展中逐渐出现发热、咳嗽、白痰、氧饱和度下降等下呼吸道症状;腹痛、解柏油样便,以及腹部影像学见腹腔积液,均为消化道表现;此外见典型皮肤囊性丘疹及脐凹样疹,以及颈部及腋窝浅表淋巴结肿大,影像检查见纵隔、腹膜后及肠系膜走行区淋巴结增多、肿大,较大者直径达2.0 cm。本例患者住院期间出现左侧眼睑上抬困难,伴有左侧眼球活动受限、轻度吐词不清、口角歪斜,头颈部MRI提示延髓左侧异常信号,考虑为马尔尼菲篮状菌病中枢神经系统受累的表现,较为少见,抗真菌治疗后随访上述症状均好转,复查MRI提示病灶明显缩小,进一步印证该患者为中枢神经系统受累。
2.3 影像特征马尔尼菲篮状菌病累及呼吸系统时常见的胸部CT征象为结节、磨玻璃影,斑片浸润或肺实变等一系列类似肺结核的表现,部分患者可见弥漫性粟粒样影,常同时合并纵隔及肺门淋巴结肿大和胸腔积液[27-28]。腹腔感染的CT表现有淋巴结肿大、腹腔积液、肝脾肿大,其中腹膜后及肠系膜淋巴结肿大较为常见,腹腔干旁和肠系膜区淋巴结肿大最为常见,且肿大程度更为明显[29]。MRI检查可见沿肠系膜血管边缘分布的多发淋巴结肿大伴环形强化,淋巴结之间一般界限清晰。马尔尼菲篮状菌病累及骨骼时,影像学表现有虫蛀样骨质破坏、骨膜增生等,甚至可出现骨折[30]。发射型计算机断层显像(emission CT, ECT)检查可见骨骼放射性摄取增加[31]。正电子发射计算机断层显像(Positron emission tomography-CT, PET-CT)检查可显示全身弥漫性淋巴结肿大、多处骨代谢活跃和骨质破坏[32]。
本例患者CT检查见颈部、纵隔、腹膜后及肠系膜淋巴结肿大,双侧肾上腺明显增粗,腹腔积液,均考虑为马尔尼菲篮状菌感染表现,另外延髓左侧出现的异常信号,喉镜下双侧圆枕覆盖白色伪膜样新生物,左侧咽侧壁、舌根部隆起,左侧声带后上方见囊肿样物,考虑为该病原累及中枢神经系统及上呼吸道的表现。患者经抗真菌治疗后,咽痛好转,痰液分泌减少,左侧眼睑不能睁开、左侧眼球活动受限、轻度吐词不清、口角歪斜等情况逐渐好转,经影像学复查肿大的淋巴结消失,肾上腺正常,延髓病变明显缩小。
2.4 病原学检测病原学培养出马尔尼菲篮状菌是该病确诊的金标准[23]。骨髓和淋巴结活检组织培养最为敏感,其次是皮损刮取物和外周血培养,当感染累及相应系统时在粪便、尿液、脑脊液和关节液中也可培养出马尔尼菲蓝状菌[23, 33]。疑诊马尔尼菲篮状菌感染时,须同时于25 ℃、37 ℃下行沙氏培养基培养。25 ℃培养时,马尔尼菲篮状菌以霉菌形态生长,菌落呈黄绿色或浅灰绿色,可产生红色可溶性色素,此时显微镜下观察可见扫帚状有隔菌丝,和侧生、端生的分生孢子。37 ℃培养时,菌落形似奶油,表面平滑,无色素产生;显微镜下马尔尼菲篮状菌呈圆形、卵圆形或腊肠形,多带横隔[23, 34]。虽然病原学培养阳性为诊断的金标准,但培养时间长,因此早期诊断困难,易延误治疗。血清学检测G实验及GM实验的价值有限,而淋巴结、肝脏等活组织检查中可见大量马尔尼菲篮状菌的泡沫巨噬细胞浸润,对标本进行瑞氏染色、吉姆萨染色、碘酸-雪夫染色及六铵银染色镜检可作早期诊断[35-36],镜检可见细胞内外嗜碱性、圆形或类圆形菌体,部分菌体有明确的中央隔膜[23]。近年来,真菌实验室检测新技术的应用为马尔尼菲篮状菌感染早期诊断提供了更多可能,如甘露糖蛋白(Mp1p)抗原检测体系[37]、基于聚合酶链式反应(polymerase chain reaction,PCR)的检测方法、二代测序、质谱及光谱检测技术,这些技术在马尔尼菲篮状菌早期诊断中具有广阔的应用前景[38-40]。本例患者淋巴结穿刺物镜下见典型的腊肠状酵母样微生物,同时血培养涂片镜检见丝状真菌,早期诊断为马尔尼菲篮状菌病,后经淋巴结穿刺物培养最终确诊,若能充分利用抗原等血清学检测、PCR检测方法、二代测序协助早期诊断,可更早确定治疗方案,为患者尤其是免疫缺陷患者争取更多时间。
2.5 治疗方案治疗上,建议首选两性霉素B诱导治疗,之后采用伊曲康唑巩固治疗预防复发,无法耐受两性霉素B的患者,可选择伏立康唑[41-42]。推荐两性霉素B(0.5~0.7 mg/kg·d静脉滴注2周)诱导治疗,续以伊曲康唑(200 mg口服q12h)巩固治疗,持续10周后进入二级预防。本例患者经两性霉素B诱导治疗结束,并用伊曲康唑维持治疗,目前皮肤、呼吸系统、消化系统、神经系统等表现均基本消失。患者于近期复查胸腹部CT和头颈部MRI,通过对比发现患者腋窝、纵隔、腹腔淋巴结肿大的症状基本消失,肾上腺未见增粗(见图 6)、颈部肿大淋巴结消失,延髓病变较前缩小(见图 7)。

|
|
A: Enlarged lymph nodes in neck disappeared after treatment. B: Enlarged lymph nodes in axilla disappeared after treatment. C: Increased and enlarged lymph nodes in mediastinum disappeared after treatment. D: Bilateral adrenal gland thickening were normal and enlarged lymph nodes in mediastinum disappeared after treatment. 图 6 胸部及全腹部CT检查结果(2022年11月) Fig. 6 CT examination results of chest and abdominal (November 2022) |

|
|
A, C: Enlarged lymph nodes in the anterior neck disappeared in MRI examination. B, D: Lesion on the left side of medulla oblongata shrank in MRI examination. 图 7 头颅及颈部MRI检查结果(2022年11月) Fig. 7 MRI examination results of the head and neck (November 2022) |
总之,临床医师须提高对马尔尼菲篮状菌病的认识,特别是出现典型皮疹,多部位淋巴结肿大,以及呼吸、消化、中枢神经等多个系统表现时,要考虑本病可能。结合影像学、病原学检查,以及真菌实验室检测新技术的应用,就能更好地诊断和鉴别本病,并做到早期和彻底的治疗。
| [1] |
Si ZX, Qiao JJ. Talaromyces marneffei infection[J]. N Engl J Med, 2017, 377(26): 2580.
[DOI]
|
| [2] |
Qian D, Tong CK. Talaromyces (Penicilliun) marneffei infection[J]. IDCases, 2018, 13: e00428.
[DOI]
|
| [3] |
Cao CW, Xi LY, Chaturvedi V. Talaromycosis (penicilliosis) due to Talaromyces (Penicillium) marneffei: insights into the clinical trends of a major fungal disease 60 years after the discovery of the pathogen[J]. Mycopathologia, 2019, 184(6): 709-720.
[DOI]
|
| [4] |
Alex A. Laboratory maintenance and growth of Talaromyces marneffei[J]. Curr Protoc Microbiol, 2020, 56(1): e97.
[DOI]
|
| [5] |
Pruksaphon K, Ching MMN, Nosanchuk JD, Kaltsas A, Ratanabanangkoon K, Roytrakul S, Martinez LR, Youngchim S. Characterization of a novel yeast phase-specific antigen expressed during in vitro thermal phase transition of Talaromyces marneffei[J]. Sci Rep, 2020, 10(1): 21169.
[DOI]
|
| [6] |
Hu YX, Zhang JM, Li XQ, Yang YB, Zhang Y, Ma JC, Xi LY. Penicillium marneffei infection: an emerging disease in mainland China[J]. Mycopathologia, 2013, 175(1): 57-67.
|
| [7] |
Wei HY, Liang WJ, Li B, Wei LY, Jiang AQ, Chen WD, Guo PH, Xu J. Clinical characteristics and risk factors of Talaromyces marneffei infection in human immunodeficiency virus-negative patients: a retrospective observational study[J]. World J Emerg Med, 2021, 12(4): 281-286.
[DOI]
|
| [8] |
Srinoulprasert Y, Pongtanalert P, Chawengkirttikul R, Chaiyaroj SC. Engagement of Penicillium marneffei conidia with multiple pattern recognition receptors on human monocytes[J]. Microbiol Immunol, 2009, 53(3): 162-172.
[DOI]
|
| [9] |
Zhou LL, Cao XX, Fang J, Li YH, Fan MW. Macrophages polarization is mediated by the combination of PRR ligands and distinct inflammatory cytokines[J]. Int J Clin Exp Pathol, 2015, 8(9): 10964-10974.
[PubMed]
|
| [10] |
Chen RQ, Ji GQ, Xi LY, Zhang TT, Zheng D, Li XM, Ren H. Role of autophagy in regulating the immune response of dendritic cells to Talaromyces marneffei infection[J]. Microb Pathog, 2018, 123(1): 120-125.
[DOI]
|
| [11] |
Kudeken N, Kawakami K, Saito A. Cytokine-induced fungicidal activity of human polymorphonuclear leukocytes against Penicillium marneffei[J]. FEMS Immunol Med Microbiol, 1999, 26(2): 115-124.
[DOI]
|
| [12] |
Pongpom M, Vanittanakom P, Nimmanee P, Cooper CR, Vanittanakom N. Adaption to macrophage killing by Talaromyces marneffei[J]. Future Science OA, 2017, 3(3): FSO215.
[DOI]
|
| [13] |
Rongrungruang Y, Levitz SM. Interactions of Penicillium marneffei with human leukocytes in vitro[J]. Infect Immun, 1999, 67(9): 4732-4736.
[DOI]
|
| [14] |
张建全, 钟小宁, 柳广南, 冯震博. 健康宿主合并马尔尼菲青霉病的临床特征及误诊原因分析[J]. 中华内科杂志, 2010, 49(8): 700-701. [DOI]
|
| [15] |
Li HR, Cai SX, Chen YS, Yu ME, Xu NL, Xie BS, Lin M, Hu XL. Comparison of Talaromyces marneffei infection in human immunodeficiency virus-positive and human immunodeficiency virus-negative patients from Fujian, China[J]. Chin Med J (Engl), 2016, 129(9): 1059-1065.
[DOI]
|
| [16] |
Wang YG, Cheng JM, Ding HB, Lin X, Chen GH, Zhou M, Ye SN. Study on the clinical features and prognosis of Penicilliosis Marneffei without human immunodeficiency virus infection[J]. Mycopathologia, 2018, 183(3): 551-558.
[DOI]
|
| [17] |
唐志荣, 陈杰, 温理, 李海青, 陆国敢. 艾滋病合并青霉菌病119例临床分析[J]. 中华传染病杂志, 2010, 28(9): 570-572. [CNKI]
|
| [18] |
金嘉琳, 胡越凯, 徐斌, 朱利平, 翁心华, 陈澍. 非人类免疫缺陷病毒感染马尔尼菲青霉病9例临床特征分析及文献复习[J]. 微生物与感染, 2017, 12(6): 333-339. [URI]
|
| [19] |
Zhou FL, Bi XG, Zou XL, Xu ZY, Zhang TT. Retrospective analysis of 15 cases of Penicilliosis marneffei in a southern China hospital[J]. Mycopathologia, 2014, 177(6): 271-279.
[DOI]
|
| [20] |
Lu PX, Zhu WK, Zhan NY, Liu Y, Chen XC, Ye RX, Cai LS, Zhu BP. Clinical characteristics and imaging manifestations of AIDS complicated with disseminated Penicillium marneffei infection[J]. Chin J Interv Imaging Ther, 2006, 3(1): 63-68.
[URI]
|
| [21] |
黄春兰, 韦文飞, 马丽梅. 非HIV患者播散性马尔尼菲篮状菌感染并溶骨性破坏1例[J]. 中国真菌学杂志, 2021, 16(6): 410-413. [CNKI]
|
| [22] |
张建全, 柳广南, 杨美玲, 白晶, 邓静敏, 何志义, 钟小宁. 马尔尼菲青霉病并发溶骨性破坏八例临床分析[J]. 中华临床医师杂志, 2011, 5(13): 3912-3915. [CNKI]
|
| [23] |
卢朝辉, 刘鸿瑞, 谢秀丽, 王爱霞, 刘彤华. 马尔尼菲青霉菌感染[J]. 中华病理学杂志, 2004, 33(6): 536-540. [CNKI]
|
| [24] |
吴浪龙, 钟建民, 毛定安. 马尔尼菲青霉菌病合并中枢神经系统感染致听力下降1例报告[J]. 中国当代二科杂志, 2004, 6(4): 343-344. [CNKI]
|
| [25] |
Li YY, Dong RJ, Shresthas S, Upadhyay P, Li HQ, Kuang YQ, Yang XP, Zhang YG. AIDS-associated Talaromyces marneffei central nervous system infection in patients southwestern China[J]. AIDS Res Ther, 2020, 17(1): 26.
[DOI]
|
| [26] |
刘桂红, 顾莹莹, 姜桔红, 莫明聪, 陈国勤. 播散性马尔尼菲青霉病累及中枢神经系统1例并文献复习[J]. 临床与实验病理学杂志, 2012, 28(5): 573-575. [CNKI]
|
| [27] |
龙邦媛, 王庆平, 李康, 徐刚, 卢小军. 肺部真菌感染患者的CT影像学特征分析[J]. 中华医院感染学杂志, 2016, 26(12): 2715-2717. [CNKI]
|
| [28] |
陈碧华, 刘晋新, 李子平, 江松峰, 张烈光, 黄德扬, 史红玲. 艾滋病合并马尔尼菲青霉菌感染的胸部影像表现及治疗后随访分析[J]. 中华放射学杂志, 2008, 42(6): 655-657. [DOI]
|
| [29] |
张云桂, 赵月娟, 李玉叶, 杨欣平, 劳云飞, 李惠琴. 226例艾滋病合并马尔尼菲蓝状菌病患者的影像学特征[J]. 皮肤病与性病, 2016, 38(2): 91-94. [CNKI]
|
| [30] |
史晓天, 顾玉婷, 李凯, 李春燕. 马尔尼菲蓝状菌骨感染病变的影像学分析[J]. 实用放射学杂志, 2021, 37(6): 985-988. [DOI]
|
| [31] |
孙童, 韦智晓, 王秀萍, 李俊红. 全身骨显像与SPECT/CT在马尔尼菲篮状菌感染骨破坏中的诊断价值[J]. 分子影像学杂志, 2022, 45(1): 44-48. [CNKI]
|
| [32] |
梁锐烘, 刘艳雯, 曾庆思. 免疫功能正常者马尔尼菲蓝状菌病的胸部CT及PET-CT表现[J]. 放射学实践, 2019, 34(12): 1313-1317. [CNKI]
|
| [33] |
钟华敏, 谢永强, 邓秋连, 区小冰, 黄勇. 儿童马尔尼菲青霉菌感染的鉴定及该菌酵母相的体外药敏分析[J]. 热带医学杂志, 2008, 8(9): 907-910. [CNKI]
|
| [34] |
Midgley G, Clayton YM, Hay RJ. 医学真菌学诊断彩色图谱[M]. 车雅敏, 王惠平, 译. 天津: 科技翻译出版公司, 2001: 128-129.
|
| [35] |
Lim D, Lee YS, Chang AR. Rapid diagnosis of Penicillium marneffei infection by fine needle aspiration cytology[J]. J Clin Pathol, 2006, 59(4): 443-444.
[DOI]
|
| [36] |
郑叶, 曾东, 童海涛, 杨月香, 冯艳玲, 卢洪洲. 特殊染色技术在艾滋病合并真菌病理诊断中的应用[J]. 中华临床感染病杂志, 2014, 7(3): 207-211. [DOI]
|
| [37] |
韩静, 蒋忠胜, 王刚, 张鹏, 胡家光, 韦吴迪, 张洪, 何锦豪, 李玥琪, 宁传艺, 梁浩. 广西人类免疫缺陷病毒感染者/艾滋病患者合并马尔尼菲篮状菌感染的特征及Mp1p抗原快速筛检的研究[J]. 微生物与感染, 2021, 16(1): 19-25. [DOI]
|
| [38] |
中国医药教育协会真菌病专业委员会, 国家皮肤与免疫疾病临床医学研究中心(北京大学第一医院), 国家血液疾病临床医学研究中心(北京大学人民医院). 侵袭性真菌病实验室诊断方法临床应用专家共识[J]. 中华内科杂志, 2022, 61(2): 134-141. [DOI]
|
| [39] |
王月华, 胡珊, 杨英. 病原真菌的检测技术进展[J]. 生物技术通讯, 2020, 31(1): 117-123. [CNKI]
|
| [40] |
施毅, 赵江南. 侵袭性真菌病病原学非培养实验室诊断方法[J]. 中华结核和呼吸杂志, 2019, 42(7): 500-505. [DOI]
|
| [41] |
马坚池, 席丽艳, 胡永轩. 马尔尼菲青霉病治疗进展[J]. 皮肤性病诊疗学杂志, 2010, 17(1): 64-67. [CNKI]
|
| [42] |
Ge Y, Xu ZJ, Hu YT, Huang M. Successful voriconazole treatment of Talaromyces marneffei infection in an HIV-negative patient with osteolytic lesions[J]. J Infect Chemother, 2019, 25(3): 204-207.
[DOI]
|
 2023, Vol. 18
2023, Vol. 18


